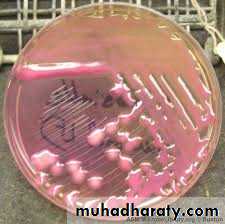
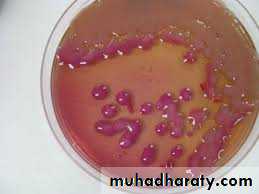
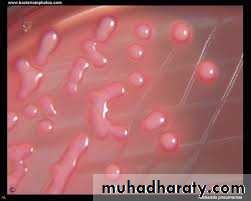
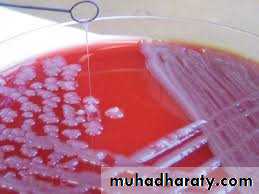
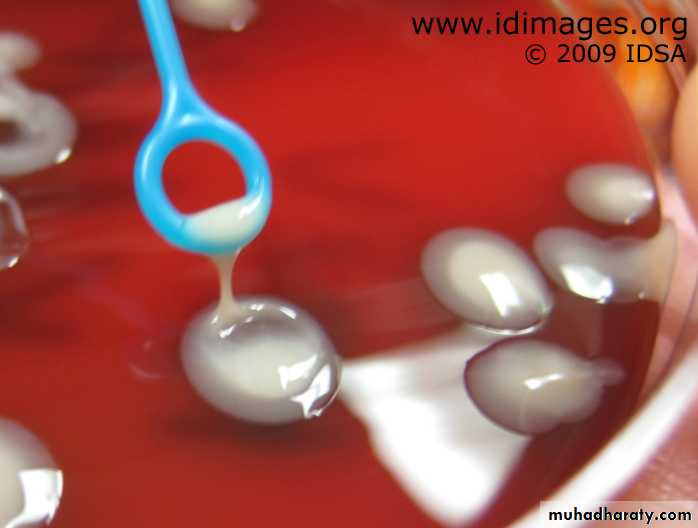
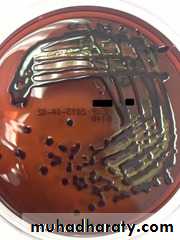
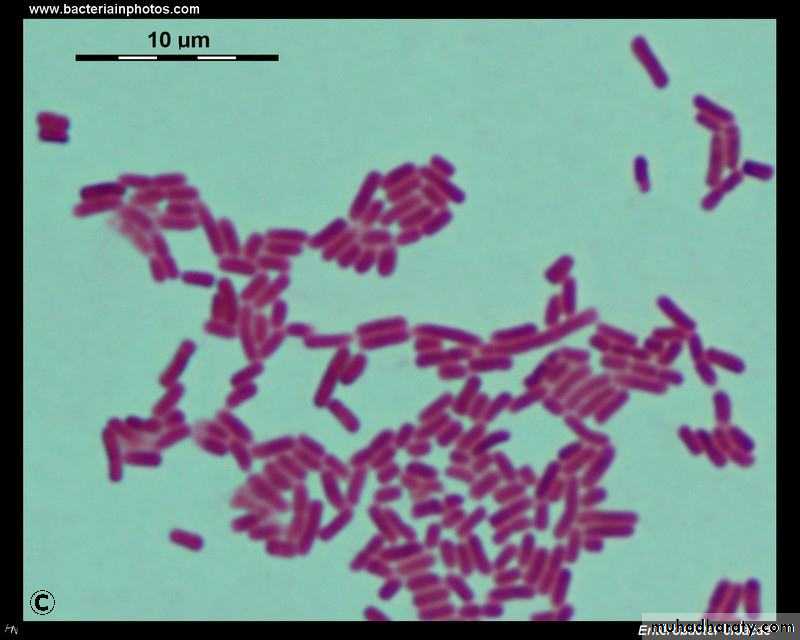
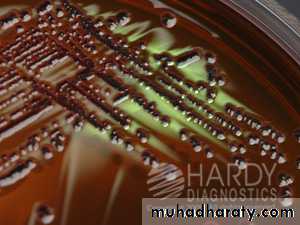
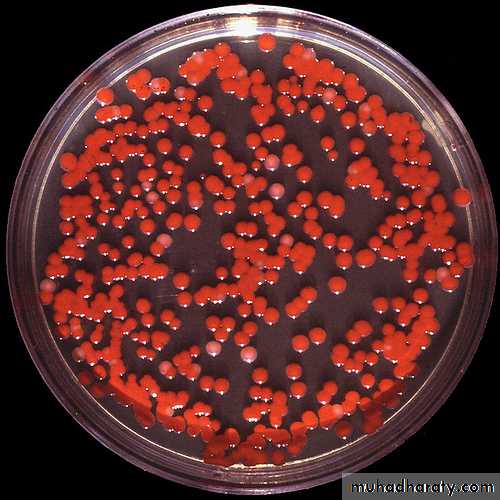
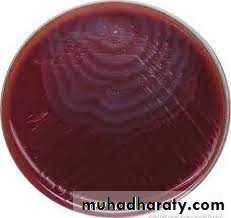
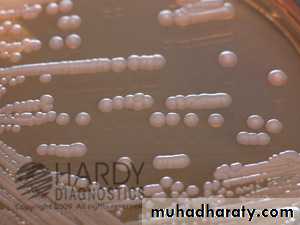
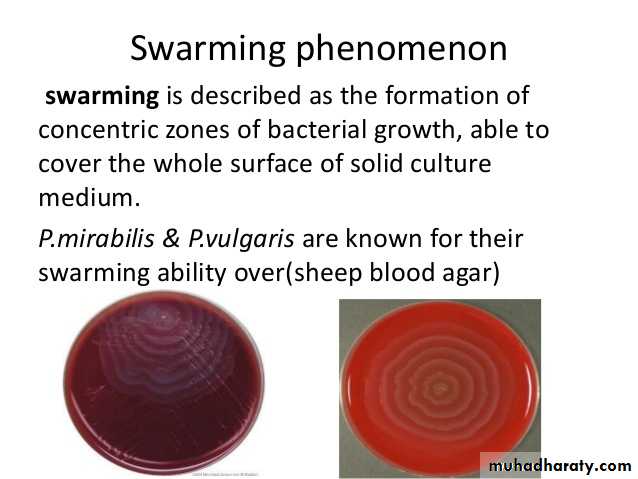
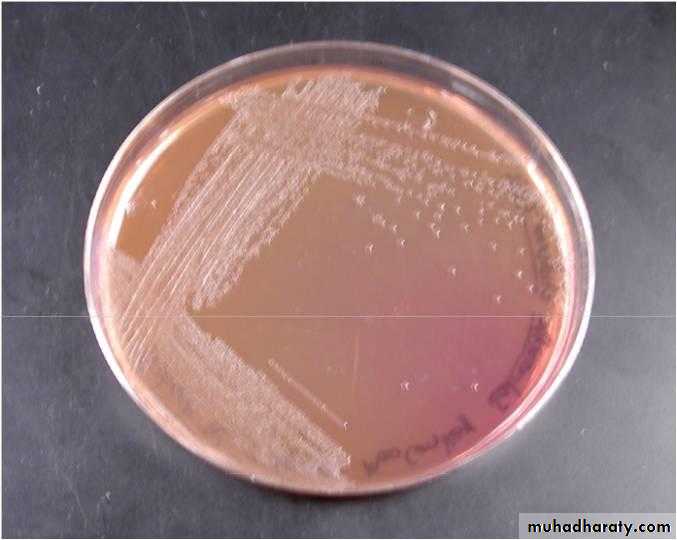
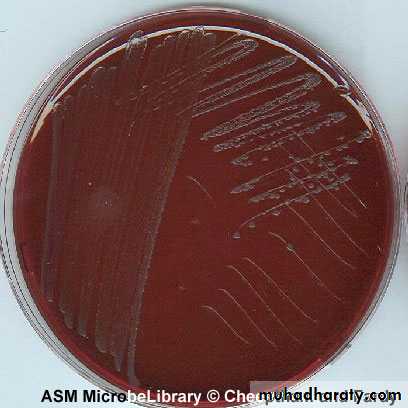
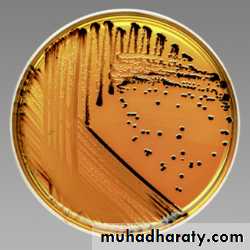
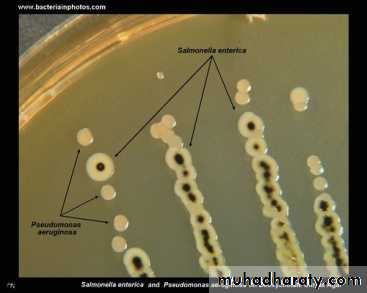
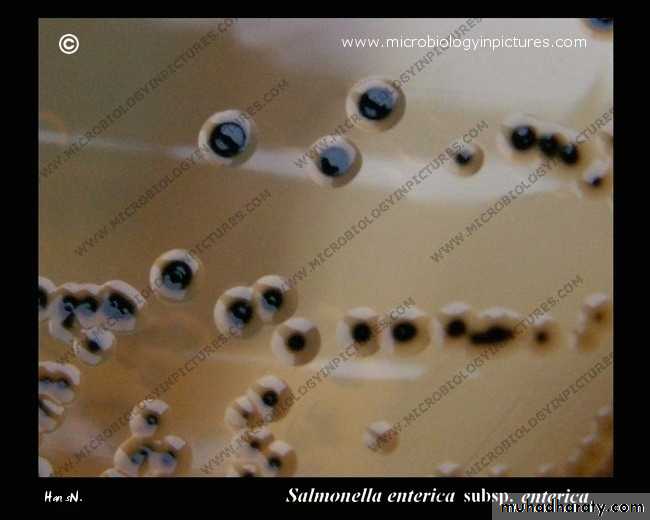
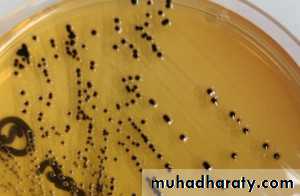
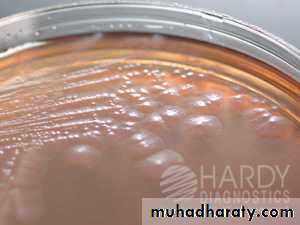
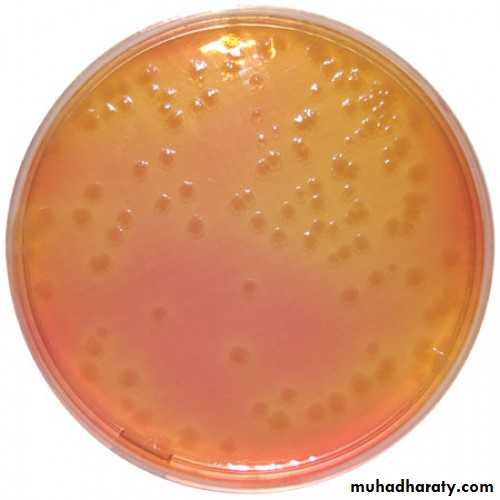
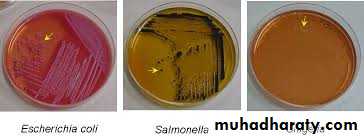

The family Enterobacteriaceae
Tribe Genus includedEscherichieae Escherichia, Shigella
Salmonelleae Salmonella
Klebsielleae klebsiella,Enterobacter, Serratia
Proteeae Proteus
Yersinieae Yersinia
Genus Klebsiella (Friedlander bacilli)
Members of this genus are foundin the intestinal tract of human and animals or free living.
These mo are associated with a wide variety of opportunstics and nosocomial infections particularly pneumonia, wound infection and UTI.
The absence of motility distinguish klebsiella from other members of enterobacteriaceae.
Kleb. Consist of several spp.:
Klebsiella pneumonia
Subspp ozaenae
Subspp rhinoscleromatis
K.oxytoca.
K. pneumoniae
Is the most common isolated spp. and has distinct feature of possessing a polysaccharide capsule which offer the mo protection against phagocytosis and antimicrobial absorption thus contributing to virulence. The capsule is responsible for moist mucoid colonies.K pneumoniae causes pneumonia and pleuritis and a frequent cause of lower respiratory tract in immune compromised. It causes 3-7% of all nosocomial infections and has the ability to harbor antibiotic resistance plasmids.
Other extrapulmonary infections are enteritis, meningitis, UTI and septicemia.
K oxytoca is identical to K pneumoniae except for its production of indoleLABORATORY DIAGNOSIS
1- Gram negative
bacilli
LABORATORY DIAGNOSIS
2- Culture:MacConkey's agar: lactose fermenter large mucoid colonies.
Mucoid colony on blood agar lactose fermenter on
MacKnokey’s agarEMB agar black colonies with green metallic sheen
TSI: A/A+ gas no H2S3- Biochemical tests:
IMViC - - + +Urease +ve
4- Motility non motile5- API
Enterobacter
Enterobacter aurogeouns
Enterobacter sakazakiiGenus Enterobacter:
They are widely distributed in nature as water and are normal commensal enteric flora. It may causes opportunistic infections as UTI, respiratory tract infection, wound infection septicemia and meningitis. Enterobacter composed of 16 spp. The clinically significant spp include E. cloacae and E aerogenes.Enterobacter has been documented as pathogen in neonatal meningitis and bacterimia, and it is isolated from brain abscesses.
LABORATORY DIAGNOSIS
Gram negative bacilli2- Culture
MacConkey’s agarLactose fermenter
EMB: blue black with metallic sheen.
TSI: yellow no H2S3- Biochemical reactions
IMViC: - - + +Urease: -
4- Motility +ve.
5- API
Serratia
The genus composed 8 spp mostimportant is Serratia marcescens.
Serratia is an important opportunistic pathogen associated pneumonia, septicemia and bacteremia.
Serratia are resistance to many antimicrobial agents. S. marcescens often produce red to pink pigment specially when incubated at room temperature.
LABORATORY DIAGNOSIS:
Gram negative bacilli.Culture:
MacConkey's agar: lactose fermenter.
EMB: blue black colonies with metallic sheen.
TSI: yellow no H2S.Biochemical tests:
IMViC: - - + +
Urease: -ve
Motility: +ve
API
Proteus
The genus proteus belong to the tribe Proteeae.
They are normal intestinal flora.
They have a characteristic swarming motility which is a wave like spreading of the MO across the entire surface of the agar.
All the members of this tribe fail to ferment lactose.
The most important spp P mirabilis and P. vulgaris.
P mirabilis causes UTI and wound infection. P. vulgaris also causes wound infection in immunocompromised and patients on antibiotic.
UTI could be upper or lower.
LABORATORY DIAGNOSIS
P mirabilis, P. vulgaris, are easily recognized in LAB by the characteristic swarming phenomena on non selective culture media (SBA). Also produce distinct oder burnt chocolate.Both spp hydrolyze urea making the urine of patient with UTI with proteus more alkaline promoting kidney stone formation by precipitation of Mg and Ca. P mirabilis is differentiated from P. vulgaris by indole (mirabilis –ve, vulgaris +ve).
All strains of P. mirabilis are sensitive to ampicillin and cephalosporin whereas P. vulgaris is resistant.
Diagnosis
1- Gram negative bacilli
2- Culture:characteristic
sweet odor
On Nutrient and blood agar
a characteristic swarming
MacConkey's agar: NLF
colorlessEMB: colorless.
TSI: K/ acid + H2S
Biochemical tests
IMViC: + + - v P.vulgaris- + - v P. mirabilis
Urease +ve
Motility +ve
API.Primary intestinal pathogens:Salmonella (transmitted from animal, human carrier)Shigella (primary human pathogen)
Salmonella
SalmonellaSalmonella is a major cause of bacterial enteric illness. Human infections are most commonly caused by ingestion of food, water or milk contaminated or due to contaminated poultry products.
Salomenlla enterica has 6 subsp.
S.enterica subsp. enterica
S. enteric subsp salamae
S.enterica subsp arizonae
S.enterica subsp diarizonae
S.enterica subsp huotenae
S.enterica subsp indica.
Virulence factors:
Enterotoxin significant virulence factor.Fimbria in adherence.
Vi Ag (resist intracellular killing by phagocyte)
Antigenic Structures:
They have the somatic O Ag and flagellar H Ag in primary structure used in serological grouping of salmonella. Some salmonella posses K surface Ag and Vi Ag .
Vi Ag it is surface polysaccharide capsule it block the O Ag in serological typing but may be removed by heating.
Salmonella
S. Typhi and S. Paratyphi are primarily infective for humans.
Other salmonellae are chiefly pathogenic in animals.
Humans usually become infected by ingestion of contaminated food or drink (mean infective dose: 106-108, but that of S. typhi is lower). In children, infections can result from direct fecal-oral spread.
The most common sources of human infections: poultry, eggs, dairy products, and foods prepared on contaminated work surfaces. However, the major source of infection for enteric fever is the carriers (convalescent or healthy permanent).
Clinical diseasesfour clinical types of infection
1- Acute gastroenteritis ( infective food poisoning):It’s the most frequent manifestation ranging from mild to severe diarrheoa accompanied by low grade fever. And varying degrees of nausea and vomiting. Symptoms appear 8-36 hr after the consumption of contaminated food. It is self limiting disease, no complications.
2. Bacteremia
Most common causal species: S. Choleraesuis, S Typhi and S. Paratyphi.Symptoms: like sepsis caused by other gram-negative bacteria. It occurs without major GI symptom characterized by high spiking fever and positive blood culture. The risk of metastatic complication more severe than the bacterimia itself. 10% of patients may have localized suppurative infections, e.g., osteomyelitis, endocarditis, arthritis, etc.
High risk population: pediatric and geriatric patients; AIDS patients.
3- Enteric fever
The early peiod(1-2wk) there will be fever, constipation during which blood cultures are positive and stool culture negative, followed by the second diarrhoeic phase during which stool culture is positive and the blood culture become negative.
The clinical features of enteric fever include the prolonged fever, bacterimia, involvement of the RES(liver, spleen, mesentery, BM) and dissemination to multiple organs.
Typhoid is caused by Salmonella serotype Typhi, other enteric fever include paratyphoid caused by Salmonella Cholerasuis and S. Paratyphi. Paratyphoid is similar to typhoid but less severe and has less fatality rate.
IP is 9-14 days when the ingested mo reach the intestine it penetrates the intestinal wall and gain entrance to lymphatic's and reach blood stream then spread to the liver, spleen, BM were they are engulfed by phagocytes and multiply intra-cellularly and released to the blood stream for the second time. The mo isolated from the blood (1st week). During the 2nd and 3rd week of the disease the mo reach the gall bladder and peyer's patches the stool culture is positive and the gall bladder is focus for carrier.
4- Carrier state:
In which persons with previous infection may continue to excrete the MO in their feces for up to one year following remission. The individual harbors the mo in the gall bladder. They excrete the mo continuously and intermittently they are important source of infection to susceptible persons.Treatment
Enteric fever and bacteremia require antibiotic treatment: chloramphenicol, ampicillin, trimethoprim-sulfamethoxazole. Surgical drainage of metastatic abscesses may be required.Salmonella enterocolitis needs only supportive therapy (antibiotic treatment may prolong the symptoms and excretion of the salmonellae). Drugs to control hypermotility of the gut should be avoided because it is easy to transform a trivial gastroenteritis into a life-threatening bacteremia by paralyzing the bowel.
Chronic carriers of S. Typhi may be cured by antibiotics alone or combined with cholecystectomy.
LABORATORY DIAGNOSIS
1- Gram negative bacilli2- Culture:
Bone marrow culture 90% sensitive (painful).
Blood culture positive in the 1st week.
Stool culture positive in the 2nd &3rd week.
Urine culture in the 2nd week,
In enterocolitis stool culture is positive.
On macConkey's agar NLF
EMB agar colorless colonies
SS agar colorless colonies with black center due to H2S production
TSI : K/A +gas+H2S
3- Motility : positive4- Biochemical tests
IMViC: - + - +
Urease: -ve
5- API test
6- Serological diagnosis: Widel test (not reliable because of the antigenic variation of S. Typhi. Many of the surface antigens of the other member of Enterobacteriaceae are shared and induce antibodies that are cross-reactive). Widal test antiO rise in the 8th -9th day, antiH rise in the 11th -12th day. 2ME for detection of IgG is useful.
7- PCR (highly sensitive and specific but no validated PCR test in common use)
Shigella
ShigellaIs a gram negative, non-motile, rod-shaped
Shigella spp. are non lactose fermenter and tend to be biochemically inert.
Humans are the only host and the infection by ingestion. Outbreaks are most common in summer.
Antigenic structure:
The shigella spp are divided into 4 major groups according to O Ag:Dysenteriae group A (15 serotypes)( 1 produce shiga toxin).
Flexiniri group B (8 serotype).
Doydii group C (19 serotype).
Sonnie group D. (1 serotype).
The most severe form of shigellosis is caused by S. dysenteriae serotype 1.
Symptoms of disease
The clinical symptoms of shigellosis range from mild diarrhoea to severe dysentery (Dysentery is characterized by the presence of blood and mucous and pus in the stool) and tenesmus, and the disease occur in epidemic dimension.
The severity depends on the Shigella serotype causing infection, dose, the immunity and age of the host.
The incubation period is 1–7 days (usually 3 days) and symptoms typically last for 1–2 weeks. Initial symptoms include watery diarrhoea, fever and fatigue.
All Shigella spp. can cause acute bloody diarrhoea.
For most Shigella serotypes illness is generally self-limiting and fatality is very rare.
Some cases were accompanied by hemolytic uremic syndrome (HUS).
Virulence and infectivity
Once ingested, Shigella spp. must survive the acidic environment of the stomach and invade the epithelial cells of the colon to enable infection.Shigella spp. multiply inside the colonic epithelial cells and spread to adjacent cells, leading to the death of the infected cells.
The colon becomes inflamed and ulcerated and the dead mucoid cells are shed, resulting in the bloody mucoid diarrhoea often characteristic of Shigella infection.
S. dysenteriae serotype 1 strains produce the potent Shiga toxin which has cytotoxic, enterotoxic and neurotoxic effects.
Mode of transmission Shigella
spp. are transmitted by the faecal-oral route by either person-to-person contact, or consumption of contaminated food or water.LABORATORY DIAGNOSIS
The diagnosis of shigellosis is made by isolating the organism from diarrheal fecal sample cultures.1- Culture
MacConkey's agar : NLF
SS agar colorless colonies
EMB agar colorless colonies
TSI : K/A no gas no H2Soverall biochemically inert.
urea hydrolysis negative.
Motility negative
Prevention and treatment:
Hand washing before handling food and thoroughly cooking all food before eating decreases the risk of getting shigellosis.Severe dysentery can be treated with ampicillin, TMP-SMX, or fluoroquinolones, such as ciprofloxacin, and of course rehydration.
Antibiotics are usually avoided in mild cases because some Shigella species are resistant to antibiotics, and their use may make the bacteria even more resistant.
Antidiarrheal agents may worsen the sickness, and should be avoided.
Enterobacteriaceae
Opportunistic pathogensEscherichia coli
Klebsiella pneumoniae
Enterobacter aerogenes
Serratia marcescens
Proteus spp.
Providencia spp.
Citrobacter spp.
Obligate pathogens
Salmonella spp.
Shigella spp.
Yersinia spp.
Some E. coli strains
Sepsis
Meningitis
UTI
Diarrhea
Pneumonia
API
The API-20E test kit for the identification of enteric bacteria provides an easy way to inoculate and read tests relevant to members of the Family Enterobacteriaceae and associated organisms. A plastic strip holding twenty mini-test tubes is inoculated with a saline suspension of a pure culture. This process also rehydrates the dessicated medium in each tube.
After incubation in a humidity chamber for 18-24 hours at 37°C, the color reactions are read (some with the aid of added reagents), and the reactions (plus the oxidase reaction done separately) are converted to a seven-digit code which is called the Analytical Profile Index, from which name the initials "API" are derived. The code can be fed into the manufacturer's database as genus and species. The reliability of this system is very high.
• Oxidase Test
PositiveNegative
Pseudomonas
EnterobacteriaceaeIdentification of Gram's -ve rods
Nitrate test: +ve further
reduction to N2
Growth on cetrimide agar:
Pale colonies with green
pigmentation
MacConkey’s agar
& TSILactose fermenter
Pink colonies on MacConkey& acidic butt and slant on TSI
colorless colonies on MacConkey
& acidic butt alkaline slant onTSI
Lactose non-fermenter
IMViC test& EMB
IMViC
++ - -
& black colonies with metalic shines on EMB
E.coli
IMViC- - ++
Klebsiella
No H2S production
(no blacking in TSI)H2S production
(blacking in TSI)
Shigella
Urease production+ve
Proteus
-veSS agar
colorless colonies with black centers
SalmonellaO/F test: O+/F-